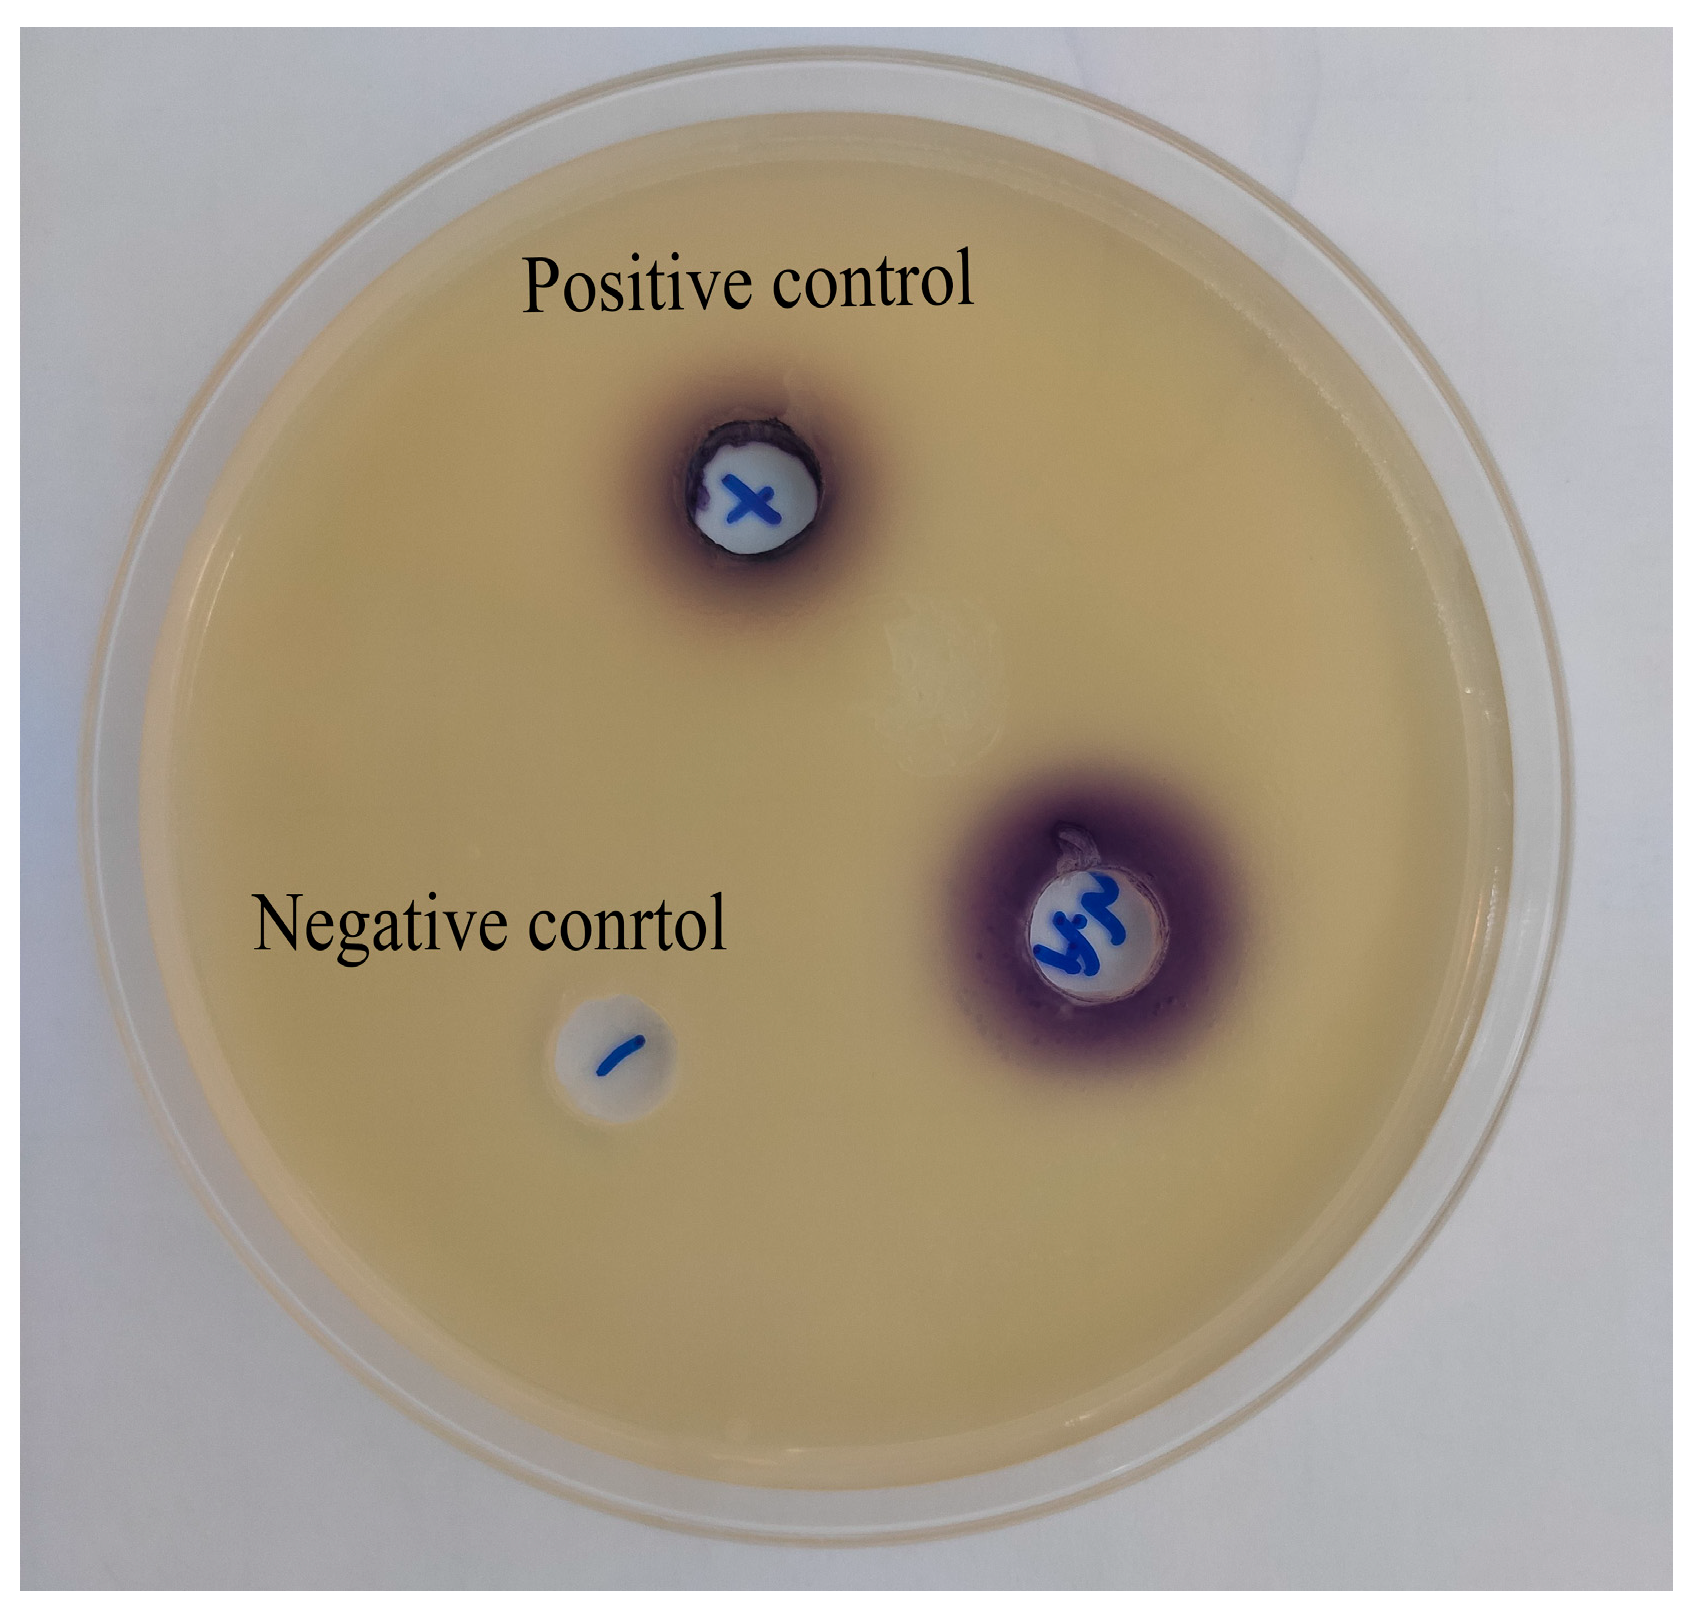
Microorganisms 11 02027 g003 Microorganisms 11 02027 g003

Carvacrol Inhibits Quorum Sensing in Opportunistic Bacterium Aeromonas hydrophila
Abstract
1. Introduction
2. Materials and Methods
2.1. Bacterial Strain and Growth Condition
2.2. Determination of Minimal Inhibitory Concentration (MIC) of Carvacrol
2.3. Quantitative Assay of Violacein Production in C. violaceum CV026
2.4. Determination AHL in A. hydrophila NJ-35
2.5. Qualitative Effect of Carvacrol Concentration on AHLs Production of A. hydrophila NJ-35
2.6. RT-qPCR Analysis
2.7. Molecular Docking Analysis
2.8. Statistical Analysis
3. Results
3.1. Antibacterial Activity of Carvacrol
3.2. Effect of Carvacrol on the Production of Violacein in C. violaceum CV026
3.3. The Presence of AHLs in A. hydrophila NJ-35
3.4. Effect of Carvacrol on AHLs Production in A. hydrophila NJ-35
3.5. Effect of Carvacrol on QS-Associated Genes of A. hydrophila
3.6. Molecular Docking
4. Discussion
5. Conclusions
Author Contributions
Funding
Data Availability Statement
Acknowledgments
Conflicts of Interest
References
- Semwal, A.; Kumar, A.; Kumar, N. A review on pathogenicity of Aeromonas hydrophila and their mitigation through medicinal herbs in aquaculture. Heliyon 2023, 9, e14088. [Google Scholar] [CrossRef] [PubMed]
- Lu, L.; Zhang, Y.; Yuan, Z.; Xu, J.; Li, M.; Wu, Y.; Wang, L.; Huang, S.; Rao, Y. Easily fabricated HARCP/HAp photocatalyst for efficient and fast removal of tetracycline under natural sunlight. Chem. Eng. J. 2021, 412, 128620. [Google Scholar] [CrossRef]
- Defoirdt, T.; Sorgeloos, P.; Bossier, P. Alternatives to antibiotics for the control of bacterial disease in aquaculture. Curr. Opin. Microbiol. 2011, 14, 251–258. [Google Scholar] [CrossRef]
- Schmidt, A.S.; Bruun, M.S.; Dalsgaard, I.; Larsen, J.L. Incidence, distribution, and spread of tetracycline resistance determinants and integrin-associated antibiotic resistance genes among motileaeromonads from a fish farming environment. Appl. Environ. Microbiol. 2001, 67, 5675–5682. [Google Scholar] [CrossRef]
- Waters, C.M.; Bassler, B.L. Quorum sensing: Cell-to-cell communication in bacteria. Annu. Rev. Cell Dev. Biol. 2005, 21, 319–346. [Google Scholar] [CrossRef]
- Qiao, Z.; Li, J.; Qin, S. Bioactive compounds for quorum sensing signal-response systems in marine phycosphere. J. Mar. Sci. Eng. 2022, 10, 699. [Google Scholar] [CrossRef]
- Xiao, Y.; Zou, H.; Li, J.; Song, T.; Lv, W.; Wang, W.; Wang, Z.; Tao, S. Impact of quorum sensing signaling molecules in gram-negative bacteria on host cells: Current understanding and future perspecti. Gut Microbes 2022, 14, e2039048. [Google Scholar] [CrossRef]
- Li, Q.; Mao, S.; Wang, H.; Ye, X. The molecular architecture of Pseudomonas aeruginosa quorum-sensing inhibitors. Mar. Drugs 2022, 20, 488. [Google Scholar] [CrossRef] [PubMed]
- Papenfort, K.; Bassler, B. Quorum sensing signal-response systems in Gramnegative bacteria. Nat. Rev. Microbiol. 2016, 14, 576–588. [Google Scholar] [CrossRef]
- Yi, L.; Dong, X.; Grenier, D.; Wang, K.; Wang, Y. Research progress of bacterial quorum sensing receptors: Classification, structure, function and characteristics. Sci. Total Environ. 2021, 763, 143031. [Google Scholar] [CrossRef]
- Nealson, K.; Hastings, J. Bacterial bioluminescence: Its control and ecological significance. Microbiol. Rev. 1979, 43, 496–518. [Google Scholar] [CrossRef] [PubMed]
- Khajanchi, B.K.; Kozlova, E.V.; Sha, J.; Popov, V.L.; Chopra, A.K. The two-component QseBC signalling system regulates in vitro and in vivo virulence of Aeromonas hydrophila. Microbiology 2012, 158, 259–271. [Google Scholar] [CrossRef]
- Stephens, K.; Bentley, W. Synthetic biology for manipulating quorum sensing in microbial consortia. Trends Microbiol. 2020, 28, 633–643. [Google Scholar] [CrossRef] [PubMed]
- Swift, S.; Karlyshev, A.V.; Fish, L.; Durant, E.L.; Winson, M.K.; Chhabra, S.R.; Williams, P.; Macintyre, S.; Stewart, G.S. Quorum sensing in Aeromonas hydrophila and Aeromonas salmonicida: Identification of the Luxri homologs ahyri and asari and their cognate N-acylhomoserine lactone signal molecules. J. Bacteriol. 1997, 179, 5271–5281. [Google Scholar] [CrossRef] [PubMed]
- Wang, Y.; Ma, S. Small molecules modulating AHL-based quorum sensing to attenuate bacteria virulence and biofilms as promising antimicrobial drugs. Curr. Med. Chem. 2014, 21, 296–311. [Google Scholar] [CrossRef]
- Deryabin, D.; Galadzhieva, A.; Kosyan, D.; Duskaev, G. Plant-derived inhibitors of AHL-mediated quorum sensing in bacteria: Modes of action. Int. J. Mol. Sci. 2019, 20, 5588. [Google Scholar] [CrossRef]
- Xiang, Y.; Ding, Y.; Cao, J.; Sun, Y.; Wang, F.; Ju, S.; Yu, J. Non-antibiotic methods against Pseudomonas aeruginosa include QS inhibitors: A narrative review. Ann. Palliat. Med. 2021, 10, 6926–6935. [Google Scholar] [CrossRef]
- Kalia, M.; Singh, P.K.; Yadav, V.K.; Yadav, B.S.; Sharma, D.; Narvi, S.S.; Mani, A.; Agarwal, V. Structure based virtual screening for identification of potential quorum sensing inhibitors against LasR master regulator in Pseudomonas aeruginosa. Microb. Pathog. 2017, 107, 136–143. [Google Scholar] [CrossRef]
- Cosa, S.; Chaudhary, S.K.; Chen, W.; Combrinck, S.; Viljoen, A. Exploring common culinary herbs and spices as potential anti-quorum sensing agents. Nutrients 2019, 11, 739. [Google Scholar] [CrossRef]
- Suntres, Z.E.; Coccimiglio, J.; Alipour, M. The bioactivity and toxicological actions of carvacrol. Crit. Rev. Food Sci. 2015, 55, 304–318. [Google Scholar] [CrossRef]
- Wang, J.; Qin, T.; Chen, K.; Pan, L.; Xie, J.; Xi, B. Antimicrobial and antivirulence activities of carvacrol against pathogenic Aeromonas hydrophila. Microorganisms 2022, 10, 2170. [Google Scholar] [CrossRef] [PubMed]
- Tapia-Rodriguez, M.R.; Hernandez-Mendoza, A.; Gonzalez-Aguilar, G.A.; Martinez-Tellez, M.A.; Martins, C.M.; Ayala-Zavala, J.F. Carvacrol as potential quorum sensing inhibitor of Pseudomonas aeruginosa and biofilm production on stainless steel surfaces. Food Control 2017, 75, 255–261. [Google Scholar] [CrossRef]
- Li, M.; Xi, B.; Qin, T.; Chen, K.; Xie, J. Isolation and characterization of AHL-degrading bacteria from fish and pond sediment. J. Ocean. Limnol. 2019, 37, 1460–1467. [Google Scholar] [CrossRef]
- Arendrup, M.C.; Prakash, A.; Meletiadis, J.; Sharma, C.; Chowdhary, A. Comparison of EUCAST and CLSI reference microdilution MICs of eight antifungal compounds for Candida auris and associated tentative epidemiological cutoff values. Antimicrob Agents Chemother. 2017, 61, e00485-17. [Google Scholar] [CrossRef]
- Devi, S.; Chhibber, S.; Harjai, K. Optimization of cultural conditions for enhancement of anti-quorum sensing potential in the probiotic strain Lactobacillus rhamnosus GG against Pseudomonas aeruginosa. 3 Biotech 2022, 12, 133. [Google Scholar] [CrossRef]
- Saha, S.; Aggarwal, S.; Singh, D.V. Attenuation of quorum sensing system and virulence in Vibrio cholerae by phytomolecules. Front. Microbiol. 2023, 14, 1133569. [Google Scholar] [CrossRef]
- Cheng, K.C.; Hsiao, H.C.; Hou, Y.C.; Hsieh, C.W.; Hsu, H.Y.; Chen, H.Y.; Lin, S.P. Improvement in violacein production by utilizing formic acid to induce quorum sensing in Chromobacterium violaceum. Antioxidants 2022, 11, 849. [Google Scholar] [CrossRef]
- Ravn, L.; Christensen, A.B.; Molin, S.; Givskov, M.; Gram, L. Methods for detecting acylated homoserine lactones produced by Gram-negative bacteria and their application in studies of AHL-production kinetics. J. Microbiol. Meth 2001, 44, 239–251. [Google Scholar] [CrossRef]
- Wang, J.; Quan, C.; Wang, X.; Zhao, P.; Fan, S. Extraction, purification and identification of bacterial signal molecules based on N-acyl homoserine lactones. Microb. Biotechnol. 2011, 4, 479–490. [Google Scholar] [CrossRef]
- Pfaffl, M. A new mathematical model for relative quantification in real-time RT-PCR. Nucleic Acids Res. 2001, 29, e45. [Google Scholar] [CrossRef]
- Sun, B.; Luo, H.; Jiang, H.; Wang, Z.; Jia, A. Inhibition of quorum sensing and biofilm formation of esculetin on Aeromonas hydrophila. Front. Microbiol. 2021, 12, 737626. [Google Scholar] [CrossRef]
- Gao, J.; Xi, B.; Chen, K.; Song, R.; Qin, T.; Xie, J.; Pan, L. The stress hormone norepinephrine increases the growth and virulence of Aeromonas hydrophila. Microbiologyopen 2019, 8, e00664. [Google Scholar] [CrossRef]
- Mukherjee, S.; Bassler, B. Bacterial quorum sensing in complex and dynamically changing environments. Nat. Rev. Microbiol. 2019, 17, 371–382. [Google Scholar] [CrossRef]
- Khajanchi, B.K.; Sha, J.; Kozlova, E.V.; Erova, T.E.; Suarez, G.; Sierra, J.C.; Popov, V.L.; Horneman, A.J.; Chopra, A.K. N-Acylhomoserine lactones involved in quorum sensing control the type VI secretion system, biofilm formation, protease production, and in vivo virulence in a clinical isolate of Aeromonas hydrophila. Microbiology 2009, 155, 3518–3531. [Google Scholar] [CrossRef]
- Lu, L.; Li, M.; Yi, G.; Liao, L.; Cheng, Q.; Zhu, J.; Zhang, B.; Wang, C.Y.; Zeng, M. Screening strategies for quorum sensing inhibitors in combating bacterial infections. J. Pharm. Anal. 2022, 12, 1–14. [Google Scholar] [CrossRef] [PubMed]
- Ultee, A.; Kets, E.; Smid, E. Mechanisms of action of carvacrol on the food-borne pathogen Bacillus cereus. Appl. Environ. Microb. 1999, 65, 4606–4610. [Google Scholar] [CrossRef] [PubMed]
- Ojo-Fakunle, V.T.; Woertman, J.; Veldhuizen, E.J.; Burt, S.A. Sub-lethal concentrations of carvacrol (from oregano) inhibit bacterial quorum sensing and formation of biofilms. Planta Med. 2013, 79, SL51. [Google Scholar] [CrossRef]
- Tapia-Rodriguez, M.R.; Bernal-Mercado, A.T.; Gutierrez-Pacheco, M.M.; Vazquez-Armenta, F.J.; Hernandez-Mendoza, A.; Gonzalez-Aguilar, G.A.; Martinez-Tellez, M.A.; Nazzaro, F.; Ayala-Zavala, J.F. Virulence of Pseudomonas aeruginosa exposed to carvacrol: Alterations of the quorum sensing at enzymatic and gene levels. J. Cell Commun. Signal. 2019, 13, 531–537. [Google Scholar] [CrossRef] [PubMed]
- McClean, K.H.; Winson, M.K.; Fish, L.; Taylor, A.; Chhabra, S.R.; Camara, M.; Daykin, M.; Lamb, J.H.; Swift, S.; Bycroft, B.W.; et al. Quorum sensing and Chromobacterium violaceum: Exploitation of violacein production and inhibition for the detection of N-acylhomoserine lactones. Microbiology 1997, 143, 3703–3711. [Google Scholar] [CrossRef]
- Burt, S.A.; Ojo-Fakunle, V.T.A.; Woertman, J.; Veldhuizen, E.J.A. The natural antimicrobial carvacrol inhibits quorum sensing in Chromobacterium violaceum and reduces bacterial biofilm formation at sub-lethal concentrations. PLoS ONE 2014, 9, e93414. [Google Scholar] [CrossRef]
- Jahid, I.K.; Lee, N.Y.; Kim, A.; Ha, S.D. Influence of glucose concentrations on biofilm formation, motility, exoprotease production, and quorum sensing in Aeromonas hydrophila. J. Food Prot. 2013, 76, 239–247. [Google Scholar] [CrossRef] [PubMed]
- Kirke, D.F.; Swift, S.; Lynch, M.J.; Williams, P. The Aeromonas hydrophila LuxR homologue AhyR regulates the N-acyl homoserine lactone synthase, AhyI positively and negatively in a growth phase-dependent manner. Fems Microbiol. Lett. 2004, 241, 109–117. [Google Scholar] [CrossRef] [PubMed]
- Chu, W.; Jiang, Y.; Liu, Y.; Zhu, W. Role of the quorum-sensing system in biofilm formation and virulence of Aeromonas hydrophila. Afr. J. Microbiol. Res. 2011, 5, 5819–5825. [Google Scholar]
- Li, S.; Zhou, S.; Yang, Q.; Liu, Y.; Yang, Y.; Xu, N.; Ai, X.; Dong, J. Cinnamaldehyde decreases the pathogenesis of Aeromonas hydrophila by inhibiting quorum sensing and biofilm formation. Fishes 2023, 8, 122. [Google Scholar] [CrossRef]
- Li, T.; Sun, X.; Chen, H.; He, B.; Mei, Y.; Wang, D.; Li, J. Methyl anthranilate: A novel quorum sensing inhibitor and anti-biofilm agent against Aeromonas sobria. Food Microbiol. 2020, 86, 103356. [Google Scholar] [CrossRef] [PubMed]

| Primer | Sequence (5′→3′) | Reference |
|---|---|---|
| ahyR-F | TCTTGACGTGATGGGGTTGG | [31] |
| ahyR-R | GGCGGTGATGAACGACAGTA | |
| ahyI-F | CAGATGGGAGGTAGAAAACGAG | [31] |
| ahyI-R | TGGGTATCAGGGGTATCGAAA | |
| ropB-F | ACCGACGAAGTGGACTATCT | [32] |
| ropB-R | CGGCGTTCATAAAGGTGGAT |
| Compound | Protein | Binding Free Energy (Kcal/mol) | Hydrogen Bond Interacting Residues |
|---|---|---|---|
| Carvacrol | AhyI | −5.51 | Ser145 |
| AhyR | −4.94 | His126 | |
| C4-HSL | AhyR | −5.58 | His126 Pro124 Asn161 |
Disclaimer/Publisher’s Note: The statements, opinions and data contained in all publications are solely those of the individual author(s) and contributor(s) and not of MDPI and/or the editor(s). MDPI and/or the editor(s) disclaim responsibility for any injury to people or property resulting from any ideas, methods, instructions or products referred to in the content. |
© 2023 by the authors. Licensee MDPI, Basel, Switzerland. This article is an open access article distributed under the terms and conditions of the Creative Commons Attribution (CC BY) license (https://creativecommons.org/licenses/by/4.0/).
Share and Cite
Lu, L.; Wang, J.; Qin, T.; Chen, K.; Xie, J.; Xi, B. Carvacrol Inhibits Quorum Sensing in Opportunistic Bacterium Aeromonas hydrophila. Microorganisms 2023, 11, 2027. https://doi.org/10.3390/microorganisms11082027
Lu L, Wang J, Qin T, Chen K, Xie J, Xi B. Carvacrol Inhibits Quorum Sensing in Opportunistic Bacterium Aeromonas hydrophila. Microorganisms. 2023; 11(8):2027. https://doi.org/10.3390/microorganisms11082027
Chicago/Turabian StyleLu, Liushen, Junwei Wang, Ting Qin, Kai Chen, Jun Xie, and Bingwen Xi. 2023. "Carvacrol Inhibits Quorum Sensing in Opportunistic Bacterium Aeromonas hydrophila" Microorganisms 11, no. 8: 2027. https://doi.org/10.3390/microorganisms11082027
APA StyleLu, L., Wang, J., Qin, T., Chen, K., Xie, J., & Xi, B. (2023). Carvacrol Inhibits Quorum Sensing in Opportunistic Bacterium Aeromonas hydrophila. Microorganisms, 11(8), 2027. https://doi.org/10.3390/microorganisms11082027

